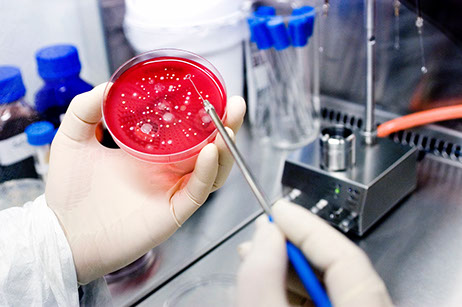
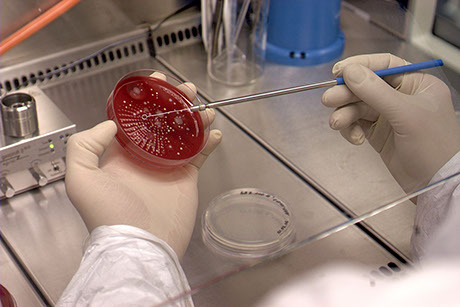

MATTHIAS GAULL
Sachkundige Person (QP) - LQK - Apotheker

ZURÜCK
Dienstleistungen für Arzneimittelhersteller
- Sachkundige Person nach §14 ff. AMG
- Personalmanagement und -suche nach qualifizierten Mitarbeitern. Z. B. LQK, LH, LQS, Mikrobiologen, Apotheker und sonstige
- Projektierung von Reinraumanlagen nach GMP (Spezialgebiet)
- Projektierung sämtlicher Verfahrensschritte zur Erlangung der Herstellungserlaubnis nach §13 AMG
- Erstellung von Qualitätsmanagementsystemen
- Inspektion von Produktionsanlagen (angemeldet/unangemeldet), von Laborbetrieben und sonstigen (mit oder ohne §13 AMG-Erlaubnis) - Großhandlungen - Einzelhandlungen
- Zulassungs- und nichtzulassungspflichtige Arzneimittel
- Medizinprodukte und Nahrungsergänzungsmittel

Herstellungsraum für Sterilarzneimittel
GMP Partikelmonitoring
BR Dreharbeiten vor Inbetriebnahme
Mikrobiologisches Monitoring
GMP-Konforme Herstellung von AM
Mikrobiologisches Monitoring
Herstellung von Zytostatikainfusionen
Mitarbeiter eines Reinraumlabors
GMP Konforme Produktion von Arzneimitteln
Herstellung nach §13 AMG/Sterilherstellung
Mikrobiologie (ausglühen)
Mikrobiologiebereich
Mikrobiologisches Monitoring laut QMS
Reinraum Glaswandsysteme
Mirkobiologisches Monitoring
1 - 15
<
>